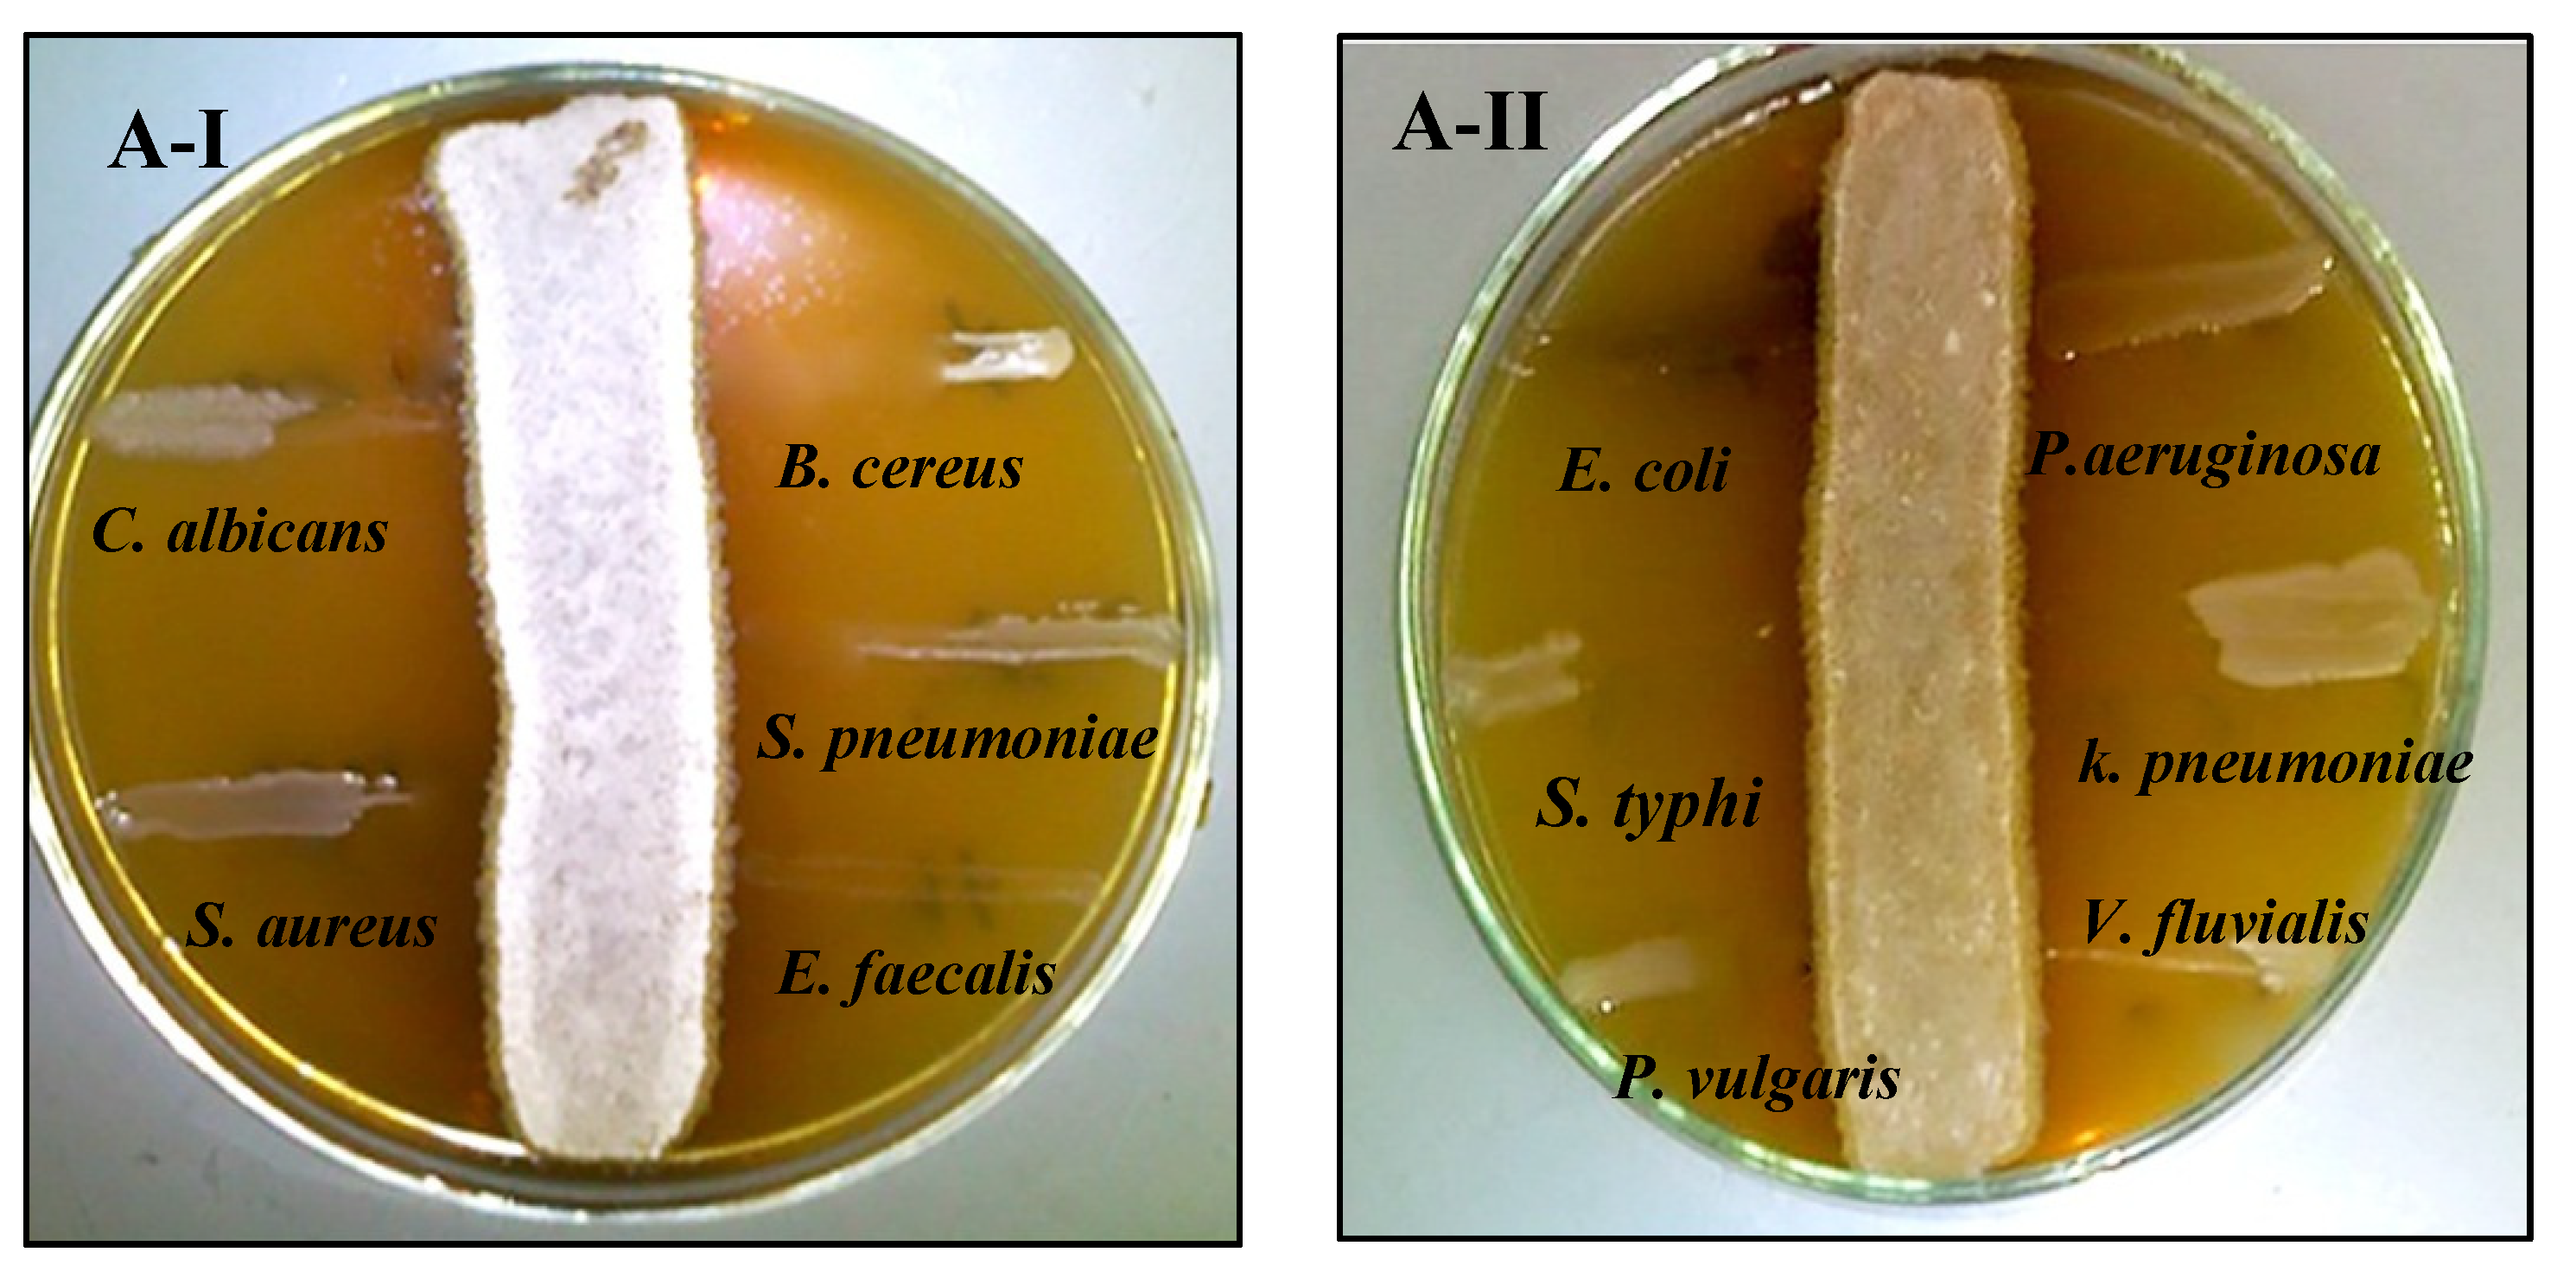
Molecules 26 03027 g003a
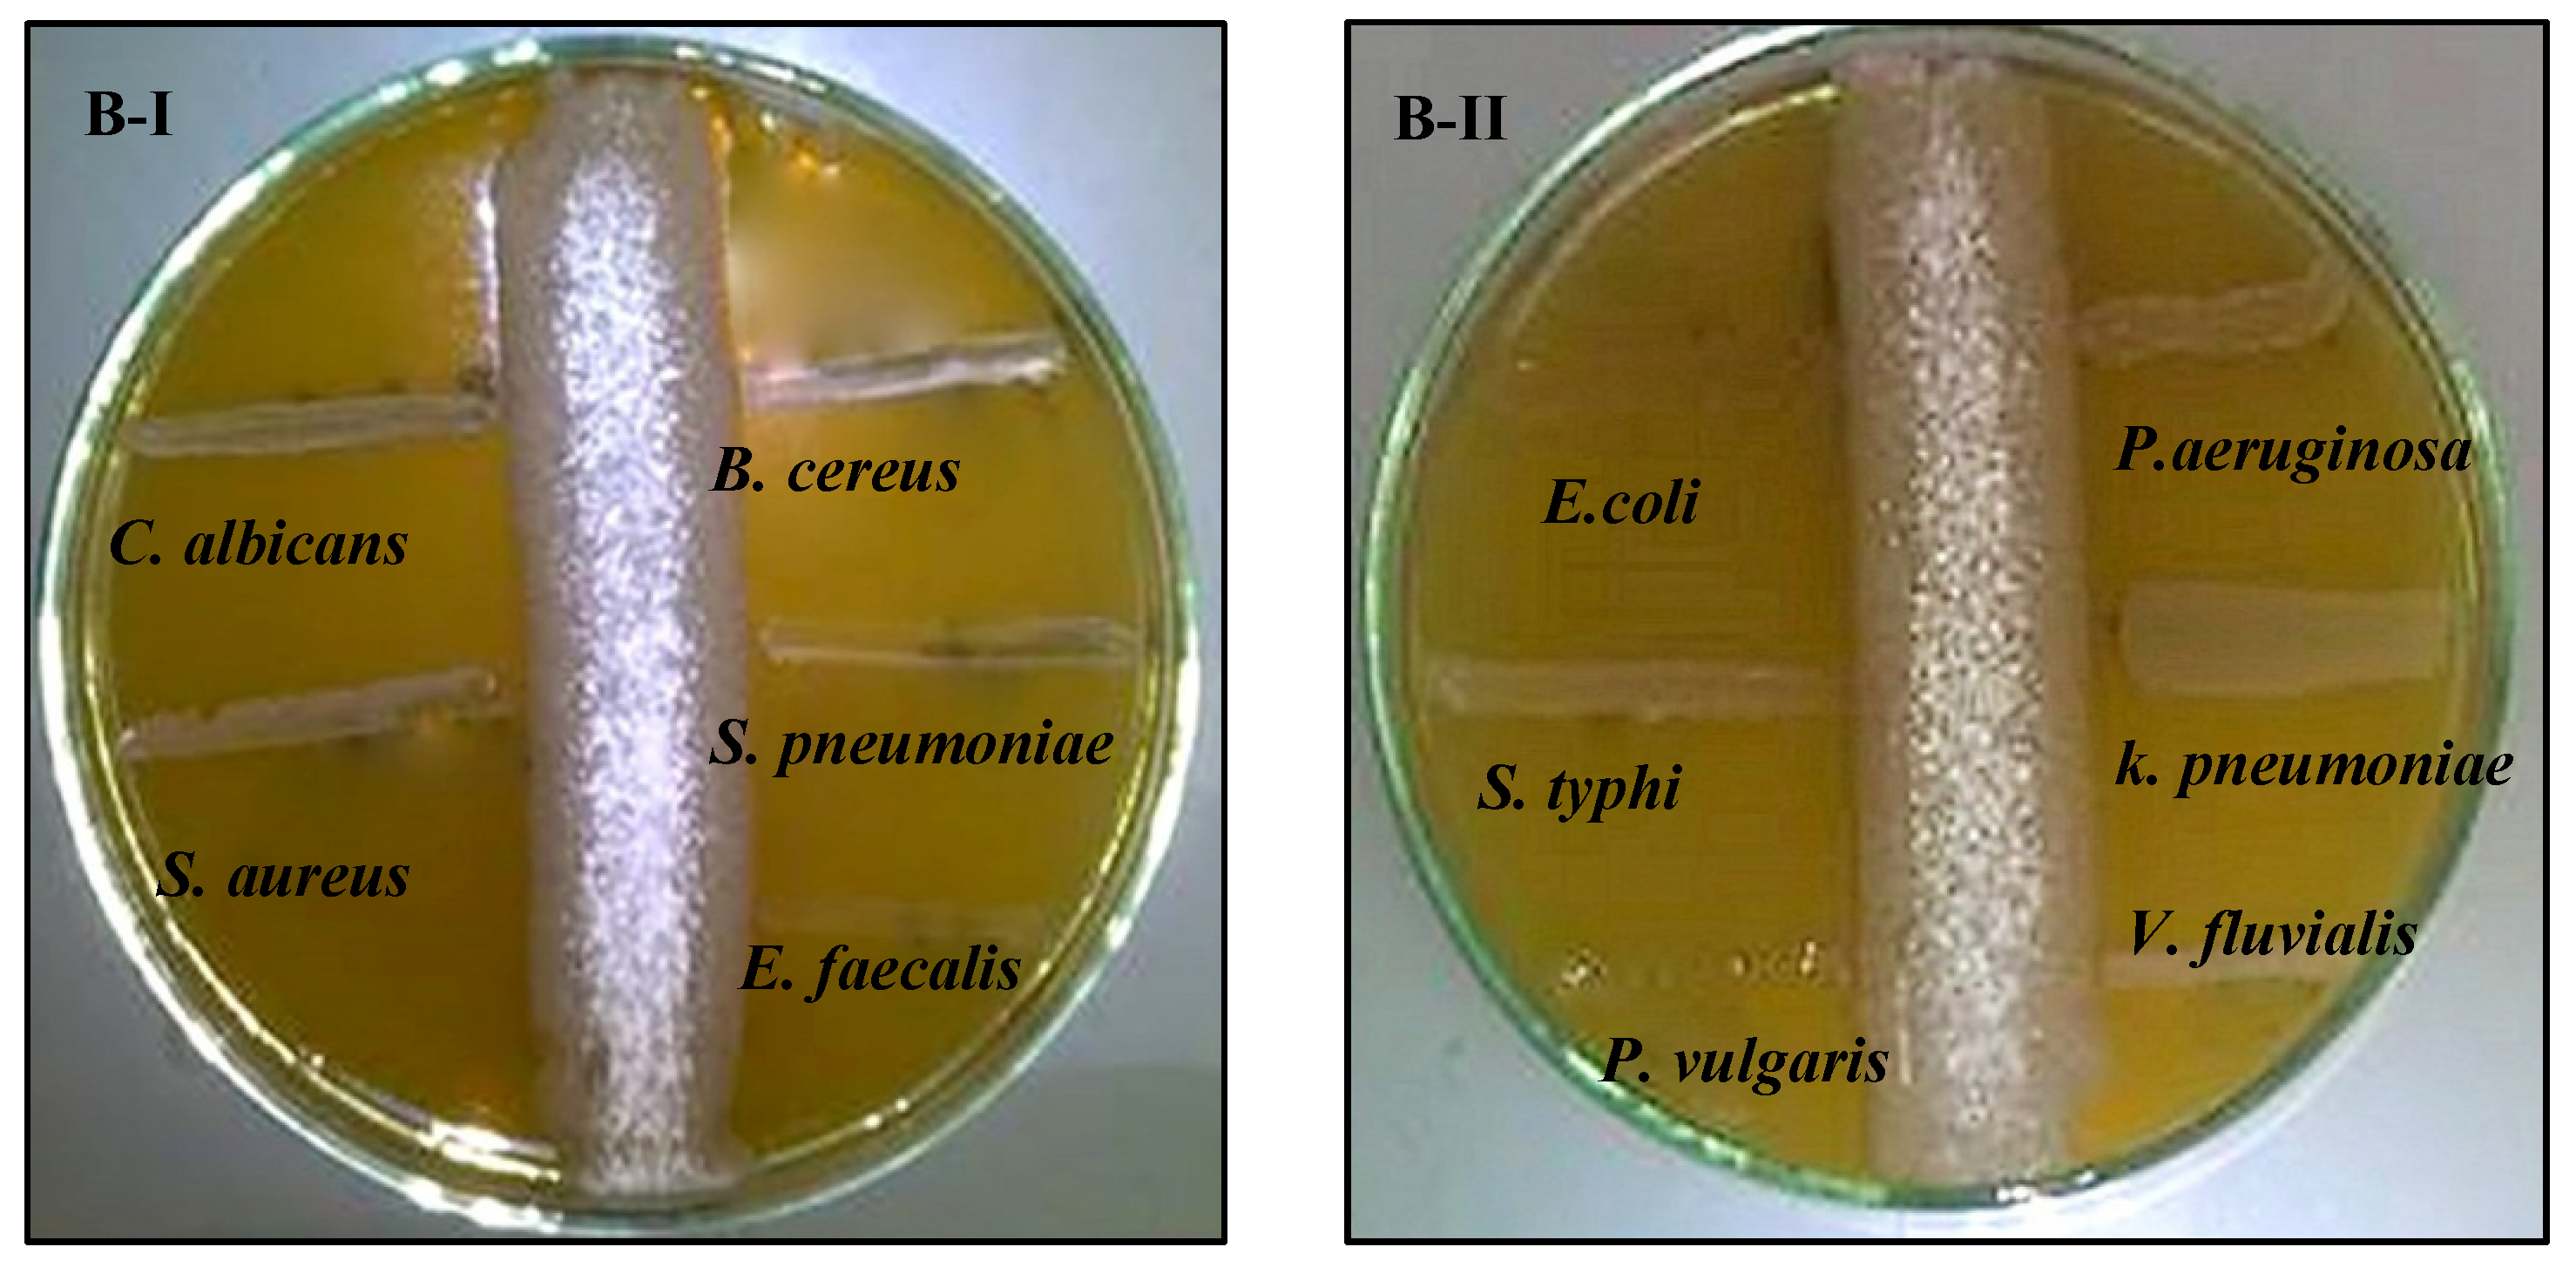
Molecules 26 03027 g003b

Antibacterial, Antifungal and Antibiofilm Activities of Silver Nanoparticles Supported by Crude Bioactive Metabolites of Bionanofactories Isolated from Lake Mariout
Abstract
:1. Introduction
2. Results
2.1. Screening, Isolation and Identification of AgNPs-Synthesizing Actinomycetes
2.2. Characterization of AgNPs-Synthesizing Actinomycetes Strains
2.2.1. Cultural and Morphological Characteristics
2.2.2. Physiological Characteristics
2.2.3. Characterization of Cell Wall Amino Acids
2.2.4. Screening of Bioactive Compounds
2.3. Synthesis of AgNPs and Evaluation of Factors Enhancing Their Productivity
2.4. Activity Determination and Molecular Detection of Nitrate Reductase Enzyme
2.5. Production and Physicochemical Characterization of Biosynthesized AgNPs
2.5.1. UV-Vis Spectroscopy
2.5.2. Energy Dispersive X-ray Analysis (EDX)
2.5.3. X-ray Diffraction (XRD)
2.5.4. Fourier-Transform Infrared (FT-IR)
2.5.5. Thermogravimetric Analysis
2.5.6. Scanning and Transmission Electron Microscopy (SEM and TEM)
2.6. Application of Biosynthesized AgNPs
2.6.1. Antimicrobial Activity of Biosynthesized AgNPs against Free-Living Pathogens
2.6.2. In Vitro Antibiofilm Efficiency of Biosynthesized AgNPs
2.6.3. Synergistic Antimicrobial-Antibiofilm Activities of AgNPs Combined with Crude Metabolite of Selected Strains
3. Discussion
4. Materials and Methods
4.1. Collection of Samples
4.2. Screening and Isolation of AgNPs-Producing Actinomycetes
4.3. Molecular Identification of Actinomycetes Isolates Synthesizing AgNPs
4.4. Characterization of the Actinomycetes Isolates Synthesizing AgNPs
4.4.1. Cultural Characteristics on Different Media
4.4.2. Morphological Characteristics
4.4.3. Physiological Characteristics
4.4.4. Characterization of Cell Wall Amino Acids
4.4.5. Screening of Bioactive Compounds
4.5. Synthesis of AgNPs and Evaluation of Factors Enhancing Their Productivity
4.6. Activity Determination and Molecular Detection of Nitrate Reductase Enzyme
4.7. Production and Physicochemical Characterization of Biosynthesized AgNPs
4.8. Application of Biosynthesized AgNPs
4.8.1. Antimicrobial Activity of Biosynthesized AgNPs
4.8.2. In Vitro Antibiofilm Efficiency of Biosynthesized AgNPs
4.8.3. Synergistic Antimicrobial-Antibiofilm Activities of AgNPs Combined with Crude Metabolite of Selected Isolates
4.9. Data Analysis
5. Conclusions
Author Contributions
Funding
Institutional Review Board Statement
Informed Consent Statement
Data Availability Statement
Acknowledgments
Conflicts of Interest
Sample Availability
References
- El Zokm, G.M.; Tadros, H.R.Z.; Okbah, M.A.; Ibrahim, G.H. Eutrophication assessment using TRIX and Carlson’s indices in lake mariout water, Egypt. Egypt. J. Aquat. Biol. Fish. 2018, 22, 321–349. [Google Scholar] [CrossRef] [Green Version]
- Mohamedin, A.; El-Naggar, N.E.-A.; Hamza, S.S.; Sherief, A. Green Synthesis, Characterization and Antimicrobial Activities of Silver Nanoparticles by Streptomyces viridodiastaticus SSHH-1 as a Living Nanofactory: Statistical Optimization of Process Variables. Curr. Nanosci. 2015, 11, 640–654. [Google Scholar] [CrossRef]
- Ahmed, S.M. Impact of different pollutants on some water quality aspects of Lake Mariout, Egypt. Egypt. J. Aquac. 2021, 10, 17–37. [Google Scholar] [CrossRef]
- Donia, N.; Bahgat, M. Water quality management for Lake Mariout. Ain Shams Eng. J. 2016, 7, 527–541. [Google Scholar] [CrossRef] [Green Version]
- Abu El-Magd, S.A.; Taha, T.; Pienaar, H.; Breil, P.; Amer, R.; Namour, P. Assessing heavy metal pollution hazard in sediments of Lake Mariout, Egypt. J. Afr. Earth Sci. 2021, 176, 104116. [Google Scholar] [CrossRef]
- Azarbad, H.; Van Gestel, C.A.; Niklińska, M.; Laskowski, R.; Röling, W.F.M.; Van Straalen, N.M. Resilience of soil microbial communities to metals and additional stressors: DNA-based approaches for assessing “stress-on-stress” responses. Int. J. Mol. Sci. 2016, 17, 933. [Google Scholar] [CrossRef] [PubMed] [Green Version]
- Ford, T. Pollutant effects on the microbial ecosystem. Environ. Health Perspect. 1994, 102, 45–48. [Google Scholar] [CrossRef] [PubMed]
- Benmalek, Y.; Fardeau, M.-L. Isolation and characterization of metal-resistant bacterial strain from wastewater and evaluation of its capacity in metal-ions removal using living and dry bacterial cells. Int. J. Environ. Sci. Technol. 2016, 13, 2153–2162. [Google Scholar] [CrossRef] [Green Version]
- Alsharif, S.M.; Salem, S.S.; Abdel-Rahman, M.A.; Fouda, A.; Eid, A.M.; Hassan, S.E.-D.; Awad, M.A.; Mohamed, A.A. Multifunctional properties of spherical silver nanoparticles fabricated by different microbial taxa. Heliyon 2020, 6, e03943. [Google Scholar] [CrossRef] [PubMed]
- Salem, S.S.; El-Belely, E.F.; Niedbała, G.; Alnoman, M.M.; Hassan, S.E.-D.; Eid, A.M.; Shaheen, T.I.; Elkelish, A.; Fouda, A. Bactericidal and In-Vitro Cytotoxic Efficacy of Silver Nanoparticles (Ag-NPs) Fabricated by Endophytic Actinomycetes and Their Use as Coating for the Textile Fabrics. Nanomaterials 2020, 10, 2082. [Google Scholar]
- Soliman, A.M.; Abdel-Latif, W.; Shehata, I.H.; Fouda, A.; Abdo, A.M.; Ahmed, Y.M. Green Approach to Overcome the Resistance Pattern of Candida spp. Using Biosynthesized Silver Nanoparticles Fabricated by Penicillium chrysogenum F9. Biol. Trace Elem. Res. 2021, 199, 800–811. [Google Scholar] [CrossRef]
- Kharissova, O.V.; Kharisov, B.I.; González, C.M.O.; Méndez, Y.P.; López, I. Greener synthesis of chemical compounds and materials. R. Soc. Open Sci. 2019, 6, 191378. [Google Scholar] [CrossRef] [PubMed] [Green Version]
- Talapko, J.; Matijević, T.; Juzbašić, M.; Antolović-Požgain, A.; Škrlec, I. Antibacterial activity of silver and its application in dentistry, cardiology and dermatology. Microorganisms 2020, 8, 1400. [Google Scholar] [CrossRef]
- Patra, J.K.; Baek, K.H. Antibacterial activity and synergistic antibacterial potential of biosynthesized silver nanoparticles against foodborne pathogenic bacteria along with its anticandidal and antioxidant effects. Front. Microbiol. 2017, 8, 1–14. [Google Scholar] [CrossRef] [PubMed] [Green Version]
- Wypij, M.; Czarnecka, J.; Świecimska, M.; Dahm, H.; Rai, M.; Golinska, P. Synthesis, characterization and evaluation of antimicrobial and cytotoxic activities of biogenic silver nanoparticles synthesized from Streptomyces xinghaiensis OF1 strain. World J. Microbiol. Biotechnol. 2018, 34, 1–13. [Google Scholar] [CrossRef] [PubMed] [Green Version]
- Bakhtiari-Sardari, A.; Mashreghi, M.; Eshghi, H.; Behnam-Rasouli, F.; Lashani, E.; Shahnavaz, B. Comparative evaluation of silver nanoparticles biosynthesis by two cold-tolerant Streptomyces strains and their biological activities. Biotechnol. Lett. 2020, 42, 1985–1999. [Google Scholar] [CrossRef] [PubMed]
- Timková, I.; Sedláková-Kaduková, J.; Pristaš, P. Biosorption and bioaccumulation abilities of actinomycetes/streptomycetes isolated from metal contaminated sites. Separations 2018, 5, 54. [Google Scholar] [CrossRef] [Green Version]
- Aref, M.S.; Salem, S.S. Bio-callus synthesis of silver nanoparticles, characterization, and antibacterial activities via Cinnamomum camphora callus culture. Biocatal. Agric. Biotechnol. 2020, 27, 101689. [Google Scholar] [CrossRef]
- Gu, H.; Chen, X.; Chen, F.; Zhou, X.; Parsaee, Z. Ultrasound-assisted biosynthesis of CuO-NPs using brown alga Cystoseira trinodis: Characterization, photocatalytic AOP, DPPH scavenging and antibacterial investigations. Ultrason. Sonochem. 2018, 41, 109–119. [Google Scholar] [CrossRef]
- Casjens, S. The diverse and dynamic structure of bacterial genomes. Annu. Rev. Genet. 1998, 32, 339–377. Available online: https://pubmed.ncbi.nlm.nih.gov/9928484/ (accessed on 26 February 2021). [CrossRef] [PubMed] [Green Version]
- Cases, I.; De Lorenzo, V.; Ouzounis, C.A. Transcription regulation and environmental adaptation in bacteria. Trends Microbiol. 2013, 11, 248–253. [Google Scholar] [CrossRef]
- Prakasham, R.S.; Kumar, B.S.; Kumar, Y.S.; Shankar, G.G. Characterization of silver nanoparticles synthesized by using marine isolate Streptomyces albidoflavus. J. Microbiol. Biotechnol. 2012, 22, 614–621. [Google Scholar] [CrossRef] [PubMed] [Green Version]
- Yamaguchi, T. Comparison of the Cell-Wall Composition of Morphologically Distinct. J. Bacteriol. 1965, 89, 444–453. [Google Scholar] [CrossRef] [PubMed] [Green Version]
- El-Naggar, N.E.-A.; Abdelwahed, N.A.M. Application of statistical experimental design for optimization of silver nanoparticles biosynthesis by a nanofactory Streptomyces viridochromogenes. J. Microbiol. 2014, 52, 53–63. [Google Scholar] [CrossRef] [PubMed]
- Tan, W.; Liao, T.-H.; Wang, J.; Ye, Y.; Wei, Y.-C.; Zhou, H.-K.; Xiao, Y.; Zhi, X.-Y.; Shao, Z.-H.; Lyu, L.-D.; et al. A recently evolved diflavin-containing monomeric nitrate reductase is responsible for highly efficient bacterial nitrate assimilation. J. Biol. Chem. 2020, 295, 5051–5066. [Google Scholar] [CrossRef]
- Cuevas, R.; Durán, N.; Diez, M.C.; Tortella, G.R.; Rubilar, O. Extracellular Biosynthesis of Copper and Copper Oxide Nanoparticles byStereum hirsutum, a Native White-Rot Fungus from Chilean Forests. J. Nanomater. 2015, 2015, 789089. [Google Scholar] [CrossRef] [Green Version]
- Khodadadi, B.; Bordbar, M.; Yeganeh-Faal, A.; Nasrollahzadeh, M. Green synthesis of Ag nanoparticles/clinoptilolite using Vaccinium macrocarpon fruit extract and its excellent catalytic activity for reduction of organic dyes. J. Alloys Compd. 2017, 719, 82–88. [Google Scholar] [CrossRef]
- Nasrollahzadeh, M.; Sajjadi, M.; Tahsili, M.R.; Shokouhimehr, M.; Varma, R.S. Synthesis of 1-Substituted 1H-1,2,3,4-Tetrazoles Using Biosynthesized Ag/Sodium Borosilicate Nanocomposite. Acs Omega 2019, 4, 8985–9000. [Google Scholar] [CrossRef] [Green Version]
- Kanagasubbulakshmi, S.; Kadirvelu, K. Green synthesis of Iron oxide nanoparticles using Lagenaria siceraria and evaluation of its Antimicrobial activity. Def. Life Sci. J. 2017, 2, 422–427. [Google Scholar] [CrossRef]
- Rahman, S.S.U.; Qureshi, M.T.; Sultana, K.; Rehman, W.; Khan, M.Y.; Asif, M.H.; Farooq, M.; Sultana, N. Single step growth of iron oxide nanoparticles and their use as glucose biosensor. Results Phys. 2017, 7, 4451–4456. [Google Scholar] [CrossRef]
- Eid, A.M.; Fouda, A.; Niedbała, G.; Hassan, S.E.-D.; Salem, S.S.; Abdo, A.M.; Hetta, H.F.; Shaheen, T.I. Endophytic Streptomyces laurentii Mediated Green Synthesis of Ag-NPs with Antibacterial and Anticancer Properties for Developing Functional Textile Fabric Properties. Antibiotics 2020, 9, 641. [Google Scholar] [CrossRef]
- Baygar, T.; Ugur, A. Biosynthesis of Silver Nanoparticles by Streptomyces griseorubens isolated from Soil and Their Antioxidant Activity. Iet Nanobiotechnol. 2017, 11, 286–291. [Google Scholar] [CrossRef] [PubMed]
- Baker, M.J.; Trevisan, J.; Bassan, P.; Bhargava, R.; Butler, H.J.; Dorling, K.M.; Fielden, P.R.; Fogarty, S.W.; Fullwood, N.J.; Heys, K.A.; et al. Using Fourier transform IR spectroscopy to analyze biological materials. Nat. Protoc. 2014, 9, 1771–1791. [Google Scholar] [CrossRef] [Green Version]
- Syame, S.M.; Mohamed, W.S.; Mahmoud, R.K.; Omara, S.T. Synthesis of Copper-Chitosan Nanocomposites and its Application in Treatment of Local Pathogenic Isolates Bacteria. Orient. J. Chem. 2017, 33, 2959–2969. [Google Scholar] [CrossRef]
- Hamedi, A.; Trotta, F.; Zarandi, M.B.; Zanetti, M.; Caldera, F.; Anceschi, A.; Nateghi, M.R. In Situ Synthesis of MIL-100(Fe) at the Surface of Fe3O4@AC as Highly Efficient Dye Adsorbing Nanocomposite. Int. J. Mol. Sci. 2019, 20, 5612. [Google Scholar] [CrossRef] [PubMed] [Green Version]
- Banik, M.; Patra, M.; Dutta, D.; Mukherjee, R.; Basu, T. A simple robust method of synthesis of copper–silver core–shell nano-particle: Evaluation of its structural and chemical properties with anticancer potency. Nanotechnology 2018, 29, 325102. [Google Scholar] [CrossRef]
- Tang, M.; Zhang, S.; Li, X.; Pang, X.; Qiu, H. Fabrication of magnetically recyclable Fe 3 O 4 @Cu nanocomposites with high catalytic performance for the reduction of organic dyes and 4-nitrophenol. Mater. Chem. Phys. 2014, 148, 639–647. [Google Scholar] [CrossRef]
- Rudakiya, D.M.; Pawar, K. Bactericidal potential of silver nanoparticles synthesized using cell-free extract of Comamonas acidovorans: In vitro and in silico approaches. 3 Biotech. 2017, 7, 1–12. [Google Scholar] [CrossRef] [PubMed] [Green Version]
- Hassan, S.E.-D.; Fouda, A.; Radwan, A.A.; Salem, S.S.; Barghoth, M.G.; Awad, M.A.; Abdo, A.M.; El-Gamal, M.S. Endophytic actinomycetes Streptomyces spp mediated biosynthesis of copper oxide nanoparticles as a promising tool for biotechnological applications. Jbic J. Biol. Inorg. Chem. 2019, 24, 377–393. [Google Scholar] [CrossRef]
- Ibrahim, S.; Ahmad, Z.; Manzoor, M.Z.; Mujahid, M.; Faheem, Z.; Adnan, A. Optimization for biogenic microbial synthesis of silver nanoparticles through response surface methodology, characterization, their antimicrobial, antioxidant, and catalytic potential. Sci. Rep. 2021, 11, 1–18. [Google Scholar] [CrossRef] [PubMed]
- Fouda, A.; Hassan, S.E.D.; Abdo, A.M.; El-Gamal, M.S. Antimicrobial, Antioxidant and Larvicidal Activities of Spherical Silver Nanoparticles Synthesized by Endophytic Streptomyces spp. Biol. Trace Elem. Res. 2020, 195, 707–724. [Google Scholar] [CrossRef]
- Monowar, T.; Rahman, S.; Bhore, S.J.; Raju, G.; Sathasivam, K.V. Silver Nanoparticles Synthesized by Using the Endophytic Bacterium Pantoea ananatis are Promising Antimicrobial Agents against Multidrug Resistant Bacteria. Molecules 2018, 23, 3220. [Google Scholar] [CrossRef] [Green Version]
- Sharma, D.; Misba, L.; Khan, A.U. Antibiotics versus biofilm: An emerging battleground in microbial communities. Antimicrob. Resist. Infect. Control. 2019, 8, 1–10. [Google Scholar] [CrossRef]
- Mah, T.-F.C.; O’Toole, G.A. Mechanisms of biofilm resistance to antimicrobial agents. Trends Microbiol. 2001, 9, 34–39. [Google Scholar] [CrossRef]
- Majumdar, M.K.; Majumdar, S.K. Effects of Minerals on Neomycin Production by Streptomyces fradiae. Appl. Microbiol. 1965, 13, 190–193. [Google Scholar] [CrossRef]
- Singh, D.; Rathod, V.; Ninganagouda, S.; Hiremath, J.; Singh, A.K.; Mathew, J. Optimization and characterization of silver nanoparticle by endophytic fungi penicillium sp. isolated from curcuma longa (Turmeric) and application studies against MDR E. coli and S. aureus. Bioinorg. Chem. Appl. 2014, 5251, 408021. [Google Scholar]
- Remya, M.; Vijayakumar, R. Isolation and characterization of marine antagonistic actinomycetes from West Coast of India. Med. Biol. 2008, 15, 13–19. [Google Scholar]
- Suthindhiran, K.; Jayasri, M.A.; Dipali, D.; Prasar, A. Screening and characterization of protease producing actinomycetes from marine saltern. J. Basic Microbiol. 2013, 54, 1098–1109. [Google Scholar] [CrossRef]
- Avilala, J.; Golla, N. Antibacterial and Antiviral properties of silver nanoparticles synthesized by marine actinomycetes. Int. J. Pharm. Sci. Res. 2019, 10, 1223. [Google Scholar] [CrossRef]
- Mukherjee, K.; Gupta, R.; Kumar, G.; Kumari, S.; Biswas, S.; Padmanabhan, P. Synthesis of silver nanoparticles by Bacillus clausii and computational profiling of nitrate reductase enzyme involved in production. J. Genet. Eng. Biotechnol. 2018, 16, 527–536. [Google Scholar] [CrossRef] [PubMed]
- Philippot, L.; Piutti, S.; Martin-Laurent, F.; Hallet, S.; Germon, J.C. Molecular analysis of the nitrate-reducing community from unplanted and maize-planted soils. Appl. Environ. Microbiol. 2002, 68, 6121–6128. [Google Scholar] [CrossRef] [PubMed] [Green Version]
- Mintmier, B.; McGarry, J.M.; Sparacino-Watkins, C.E.; Sallmen, J.; Fischer-Schrader, K.; Magalon, A.; McCormick, J.R.; Stolz, J.F.; Schwarz, G.; Bain, D.J.; et al. Molecular cloning, expression and biochemical characterization of periplasmic nitrate reductase from Campylobacter jejuni. Fems Microbiol. Lett. 2018, 365, 151. [Google Scholar] [CrossRef] [PubMed]
- Olaya-Abril, A.; Hidalgo-Carrillo, J.; Luque-Almagro, V.M.; Fuentes-Almagro, C.; Urbano, F.J.; Moreno-Vivián, C.; Richardson, D.J.; Roldán, M.D. Exploring the Denitrification Proteome of Paracoccus denitrificans PD1222. Front. Microbiol. 2018, 9, 1137. [Google Scholar] [CrossRef] [PubMed]
- Hartsock, A.; Shapleigh, J.P. Physiological roles for two periplasmic nitrate reductases in Rhodobacter sphaeroides 2.4.3 (ATCC 17025). J. Bacteriol. 2011, 193, 6483–6489. [Google Scholar] [CrossRef] [Green Version]
- Chen, Y.; Wang, F. Insights on nitrate respiration by Shewanella. Front. Mar. Sci. 2015, 1. [Google Scholar] [CrossRef] [Green Version]
- Farjadian, F.; Akbarizadeh, A.R.; Tayebi, L. Synthesis of novel reducing agent for formation of metronidazole-capped silver nanoparticle and evaluating antibacterial efficiency in gram-positive and gram-negative bacteria. Heliyon 2020, 6, e04747. [Google Scholar] [CrossRef]
- Gupta, A.; Singh, D.; Singh, S.K.; Singh, V.K.; Singh, A.V.; Kumar, A. Role of actinomycetes in bioactive and nanoparticle synthesis. In Role of Plant Growth Promoting Microorganisms in Sustainable Agriculture and Nanotechnology; Elsevier BV: Amsterdam, The Netherlands, 2019; pp. 163–182. [Google Scholar]
- Kumar, S.V.; Bafana, A.P.; Pawar, P.; Rahman, A.; Dahoumane, S.A.; Jeffryes, C.S. High conversion synthesis of <10 nm starch-stabilized silver nanoparticles using microwave technology. Sci. Rep. 2018, 8, 1–10. [Google Scholar]
- Alahmadi, N.S.; Betts, J.W.; Cheng, F.; Francesconi, M.G.; Kelly, S.M.; Kornherr, A.; Prior, T.J.; Wadhawan, J.D. Synthesis and antibacterial effects of cobalt-cellulose magnetic nanocomposites. Rsc Adv. 2017, 7, 20020–20026. [Google Scholar] [CrossRef] [Green Version]
- Adiguzel, A.O.; Adigüzel, S.K.; Mazmancı, B.; Tuncer, M.; Mazmanci, M.A.; Mazmanci, B. Silver nanoparticle biosynthesis from newly isolated streptomyces genus from soil. Mater. Res. Express 2018, 5, 045402. [Google Scholar] [CrossRef]
- Prabhu, Y.; Rao, K.V.; Sai, V.S.; Pavani, T. A facile biosynthesis of copper nanoparticles: A micro-structural and antibacterial activity investigation. J. Saudi Chem. Soc. 2017, 21, 180–185. [Google Scholar] [CrossRef] [Green Version]
- Chaudhary, R.G.; Tanna, J.A.; Gandhare, N.V.; Rai, A.R.; Juneja, H.D. Synthesis of nickel nanoparticles: Microscopic investigation, an efficient catalyst and effective antibacterial activity. Adv. Mater. Lett. 2015, 6, 990–998. [Google Scholar] [CrossRef]
- Franci, G.; Falanga, A.; Galdiero, S.; Palomba, L.; Rai, M.; Morelli, G.; Galdiero, M. Silver Nanoparticles as Potential Antibacterial Agents. Molecules 2015, 20, 8856–8874. [Google Scholar] [CrossRef] [Green Version]
- Siddique, M.H.; Aslam, B.; Imran, M.; Ashraf, A.; Nadeem, H.; Hayat, S.; Khurshid, M.; Afzal, M.; Malik, I.R.; Shahzad, M.; et al. Research article effect of silver nanoparticles on biofilm formation and EPS production of multidrug-resistant Klebsiella pneumonia. Hindawi BioMed Res. Int. 2020, 2020, 6398165. [Google Scholar]
- Hamed, A.A.; Kabary, H.; Khedr, M.; Emam, A.N. Antibiofilm, antimicrobial and cytotoxic activity of extracellular green-synthesized silver nanoparticles by two marine-derived actinomycete. Rsc Adv. 2020, 10, 10361–10367. [Google Scholar] [CrossRef]
- Rajan, B.M.; Kannabiran, K. Extraction and Identification of Antibacterial Secondary Metabolites from Marine Streptomyces sp. VITBRK2. Int. J. Mol. Cell. Med. 2014, 3, 130–137. [Google Scholar] [PubMed]
- Rashad, F.M.; Fathy, H.M.; El-Zayat, A.S.; Elghonaimy, A.M. Isolation and characterization of multifunctional Streptomyces species with antimicrobial, nematicidal and phytohormone activities from marine environments in Egypt. Microbiol. Res. 2015, 175, 34–47. [Google Scholar] [CrossRef]
- Seong, C.N.; Choi, J.H.; Baik, K.S. An Improved Selective Isolation of Rare Actinomycetes from Forest Soil. J. Microbiol. 2001, 39, 17–23. [Google Scholar]
- Duraipandiyan, V.; Sasi, A.; Islam, V.; Arasu, M.V.; Ignacimuthu, S. Antimicrobial properties of actinomycetes from the soil of Himalaya. J. Mycol. Méd. 2010, 20, 15–20. [Google Scholar] [CrossRef]
- Karthik, L.; Kumar, G.; Kirthi, A.V.; Rahuman, A.A.; Rao, K.V.B. Streptomyces sp. LK3 mediated synthesis of silver nanoparticles and its biomedical application. Bioprocess. Biosyst. Eng. 2014, 37, 261–267. [Google Scholar] [CrossRef]
- Składanowski, M.; Wypij, M.; Laskowski, D.; Golińska, P.; Dahm, H.; Rai, M. Silver and gold nanoparticles synthesized from Streptomyces sp. isolated from acid forest soil with special reference to its antibacterial activity against pathogens. J. Clust. Sci. 2017, 28, 59–79. [Google Scholar] [CrossRef] [Green Version]

| Strain | Medium Type | Growth | Aerial hyphae | Substrate hyphae | Pigments |
|---|---|---|---|---|---|
| Streptomyces fulvissimus EM1 | LB | Good | White | Pale yellow | None |
| Glycerol-Asparagine | Moderate | White | Pale yellow | None | |
| Casein-NO3 | Good | White | White | None | |
| Starch-NO3 | Good | Yellowish to white | Colorless to white | None | |
| Starch-casein agar | Poor to moderate | White | Colorless to white | None | |
| Kuster’s agar | Good | White | Yellow to brown | ||
| Bennet’s agar | Very good growth | White | Yellow to brown | None | |
| NB | Very good growth | White | Yellow | Pale gray | |
| ISP1 | Good | Pale gray | Yellow-orange | None | |
| ISP2 | Very good | Off-white | Colorless to white | None | |
| ISP4 | Very good | Off-white | Pale gray | None | |
| ISP5 | Very good | Off-white | Pale gray | None | |
| ISP6 | Very good | White | Brown | None | |
| ISP7 | Very good | Pink | Pale gray | -ve melanine | |
| Streptomyces mediolani EM2 | LB | No growth | None | None | None |
| Glycerol-Asparagine | No growth | None | None | None | |
| Casein-NO3 | Good | Pale yellow | White | None | |
| Starch-NO3 | Good | Yellowish to white | Colorless to white | Yellow | |
| Starch-casein agar | No growth | None | None | None | |
| Kuster’s agar | No growth | None | None | None | |
| Bennet’s agar | Moderate | Transparent to white | White | None | |
| NB | Very good | White | White to yellow | None | |
| ISP1 | Good | Pale yellow | Yellow | None | |
| ISP2 | Very good | White | White to yellow | None | |
| ISP4 | Good | Orange | Yellow | None | |
| ISP5 | Good | Transparent to white | White | None | |
| ISP6 | Good | Transparent to white | Pale gray | None | |
| ISP7 | Very good | Pink | Pale gray | -ve melanine |
| Microbial Group | Pathogen | Inhibition Zone (cm) | ||
|---|---|---|---|---|
| AgNPs | Crude Metabolites (EM1) +AgNPs | Crude Metabolites (EM2) +AgNPs | ||
| Gram-Negative | E. coli | 0.5 ± 0.05 | 1.1 ± 0.3 | 0.8 ± 0.1 |
| S. typhi | 0.3 ± 0.0 | 0.5 ± 0.05 *** | 0.3 ± 0.05 | |
| P. aeruginosa | 0.3 ± 0.0 | 0.4 ± 0.05 | 0.3 ± 0.05 | |
| P. vulgaris | 0.2 ± 0.0 | 0.6 ± 0.05 *** | 0.4 ± 0.05 | |
| K. pneumoniae | 0.3 ± 0.0 | 0.4 ± 0.05 | 0.3 ± 0.02 | |
| Gram-Positive | S. aureus | 0.5 ± 0.05 | 0.9 ± 0.1 * | 0.7 ± 0.1 * |
| B. cereus | 0.8 ± 0.05 *** | 1.5 ± 0.1 *** | 1.2 ± 0.3 *** | |
| E. faecalis | 0.7 ± 0.1 | 1.2 ± 0.2 * | 1.0 ± 0.2 * | |
| Yeast | C. albicans | 1.2 ± 0.05 | 2.0 ± 0.3 ** | 1.4 ± 0.3 * |
| Molds | A. brasiliensis | 0.8 ± 0.05 * | 1.2 ± 0.2 | 1.0 ± 0.3 |
| Alternaria sp. | 0.8 ± 0.0 | 1.2 ± 0.3 | 0.9 ± 0.2 * | |
| Biofilm Type | Inhibition % | ||||
|---|---|---|---|---|---|
| AgNPs Concentration (μg/mL) | Bioactive Metabolite Combined with 100 μg/mL AgNPs | ||||
| 50 | 100 | 150 | S. fulvissimus EM1 | S. mediolani EM2 | |
| P. vulgaris | 21.5 ± 0.65 * | 39.3 ± 1.7 * | 68.4 ± 0.8 * | 71.8 ± 1.4 * | 66.9 ± 1.4 * |
| B. cereus | 44.7 ± 2.8 | 65.9 ± 4.4 | 91.7 ± 2.5 * | 94.1 ± 3.5 * | 87.6 ± 2.4 * |
| C. albicans | 14.6 ± 2.1 | 26.4± 1.5 | 64.4 ± 2.3 * | 64.3 ± 1.2 * | 61.8 ± 1.3 * |
Publisher’s Note: MDPI stays neutral with regard to jurisdictional claims in published maps and institutional affiliations. |
© 2021 by the authors. Licensee MDPI, Basel, Switzerland. This article is an open access article distributed under the terms and conditions of the Creative Commons Attribution (CC BY) license (https://creativecommons.org/licenses/by/4.0/).
Share and Cite
Eltarahony, M.; Ibrahim, A.; El-shall, H.; Ibrahim, E.; Althobaiti, F.; Fayad, E. Antibacterial, Antifungal and Antibiofilm Activities of Silver Nanoparticles Supported by Crude Bioactive Metabolites of Bionanofactories Isolated from Lake Mariout. Molecules 2021, 26, 3027. https://doi.org/10.3390/molecules26103027
Eltarahony M, Ibrahim A, El-shall H, Ibrahim E, Althobaiti F, Fayad E. Antibacterial, Antifungal and Antibiofilm Activities of Silver Nanoparticles Supported by Crude Bioactive Metabolites of Bionanofactories Isolated from Lake Mariout. Molecules. 2021; 26(10):3027. https://doi.org/10.3390/molecules26103027
Chicago/Turabian StyleEltarahony, Marwa, Amany Ibrahim, Hadeel El-shall, Eman Ibrahim, Fayez Althobaiti, and Eman Fayad. 2021. "Antibacterial, Antifungal and Antibiofilm Activities of Silver Nanoparticles Supported by Crude Bioactive Metabolites of Bionanofactories Isolated from Lake Mariout" Molecules 26, no. 10: 3027. https://doi.org/10.3390/molecules26103027
APA StyleEltarahony, M., Ibrahim, A., El-shall, H., Ibrahim, E., Althobaiti, F., & Fayad, E. (2021). Antibacterial, Antifungal and Antibiofilm Activities of Silver Nanoparticles Supported by Crude Bioactive Metabolites of Bionanofactories Isolated from Lake Mariout. Molecules, 26(10), 3027. https://doi.org/10.3390/molecules26103027






